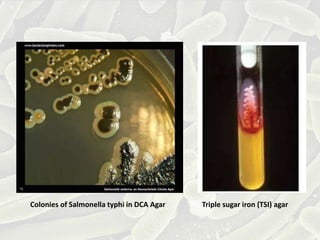
Colonies of Salmonella typhi in DCA Agar Triple sugar iron (TSI) agar

Typhoid fever, caused by Salmonella enterica serotype Typhi, leads to serious symptoms such as prolonged fever, headache, and gastrointestinal issues, and is linked to poor sanitation and lack of clean water. Annually, there are an estimated 11 to 21 million cases and significant mortality rates worldwide, with transmission primarily through the fecal-oral route. Prevention includes vaccination, proper sanitation, and antibiotic treatment, though resistance to common antibiotics is rising.

![What is the difference?
• Salmonella typhi has vi capsular polysaccharide in its
outer layer that is absent in Salmonella typhimurium.
• Typhoid fever is caused by systemic (body-wide)
infection with Salmonella enterica Typhi. In contrast,
infection with the bacterium Salmonella enterica
typhimurium is usually limited to the gut and causes
less serious diarrheal disease.
• One of the differences between [milder]
gastroenteritis and [dangerous] typhoid fever is that
the pathogen causing the latter disease evades
neutrophil chemotaxis.](https://image.slidesharecdn.com/typhoidfever-1-200326120106/85/Typhoid-fever-1-17-320.jpg)


























